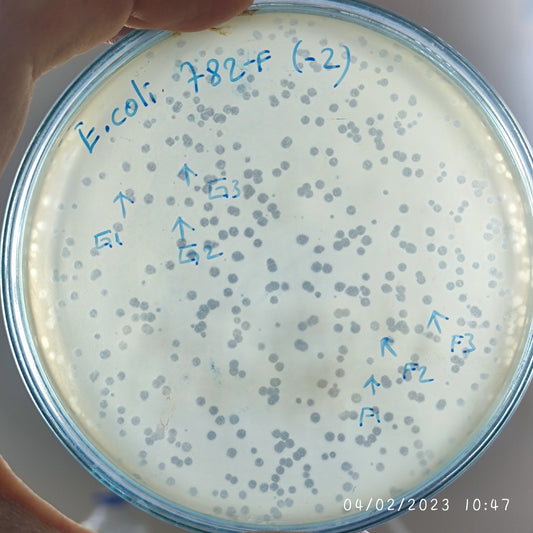
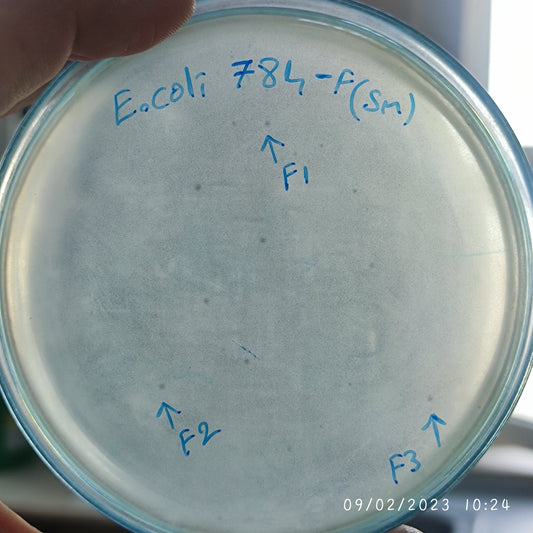
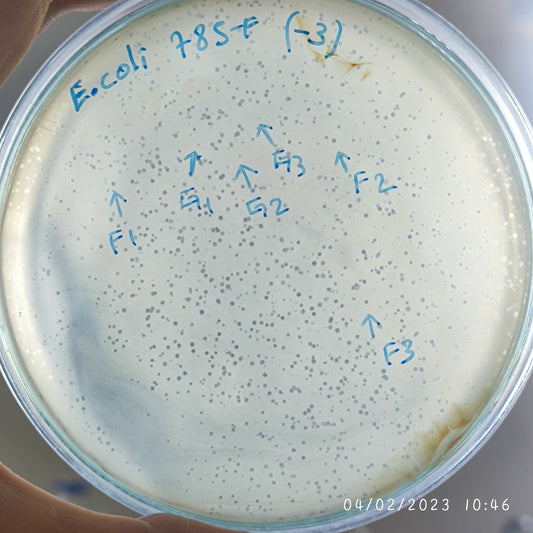
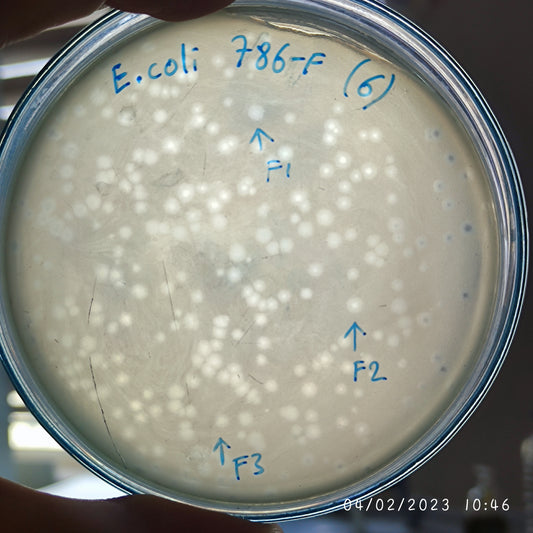
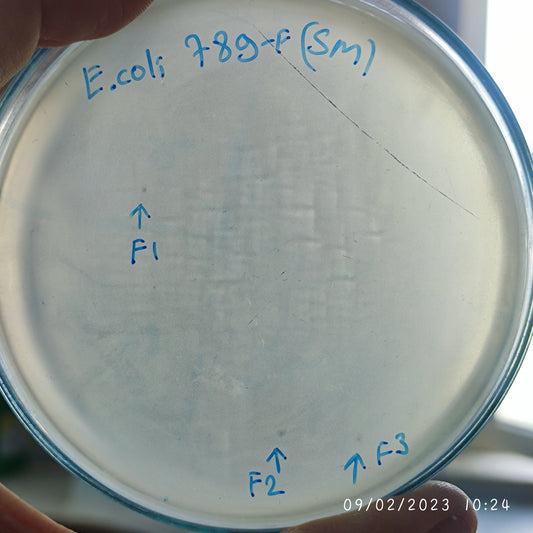
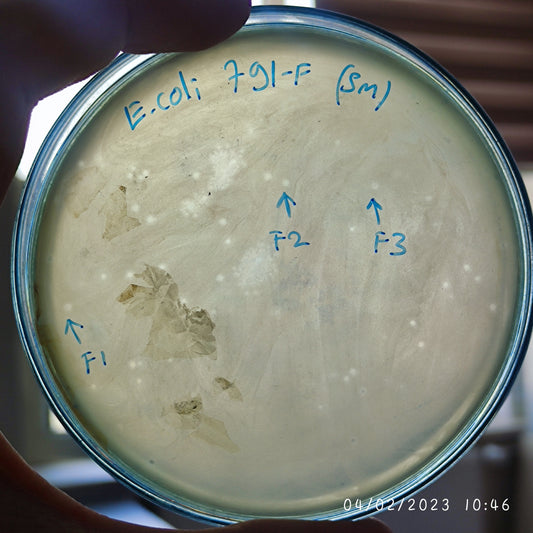
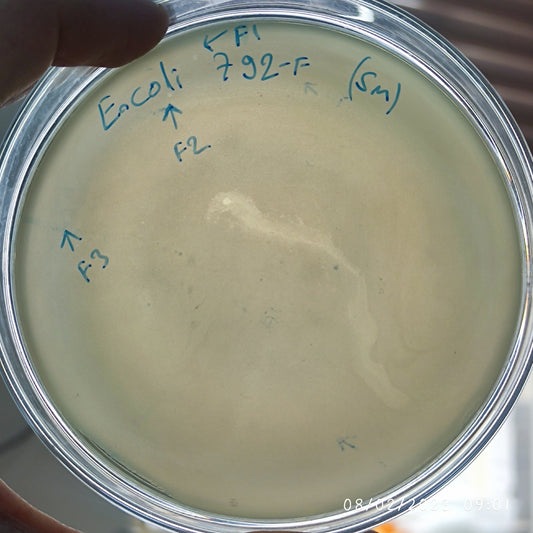
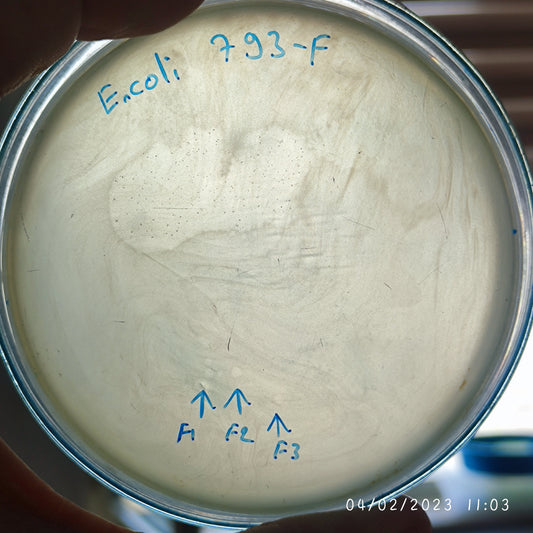
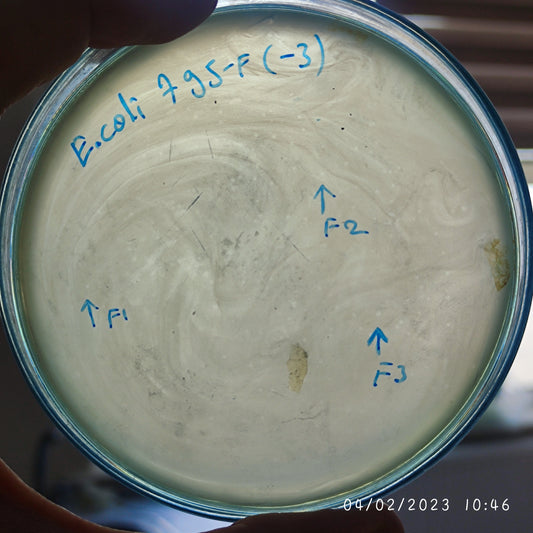
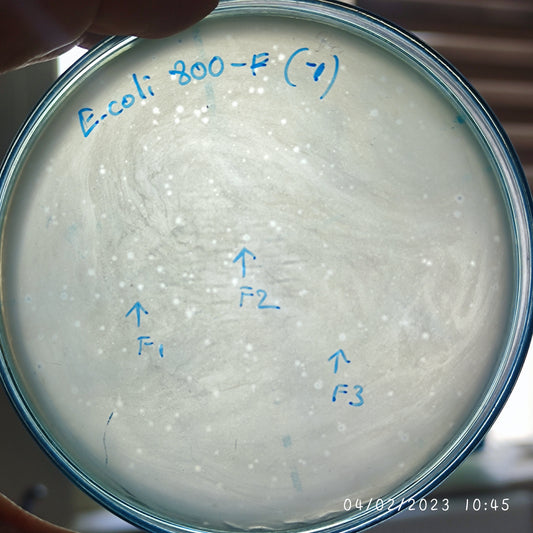
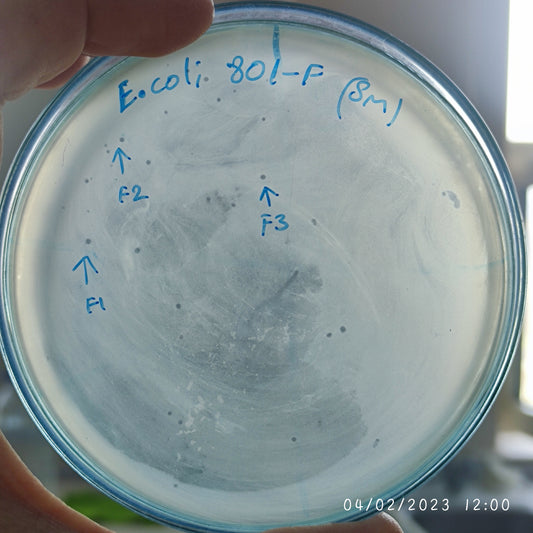
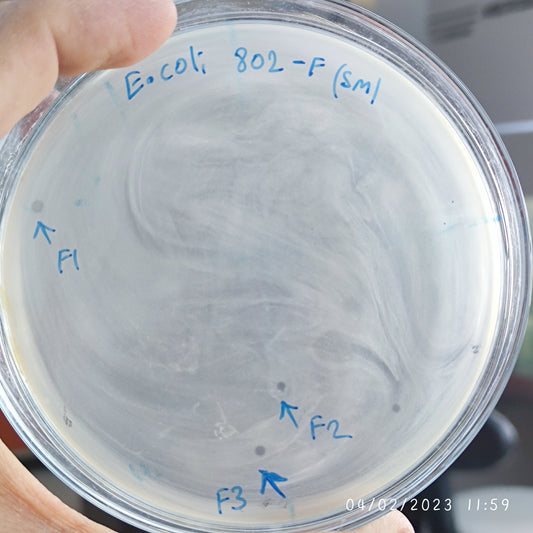

-
Escherichia coli bacteriophage 100782F
Regular price $750.00 USDRegular priceUnit price per -
Escherichia coli bacteriophage 100782G
Regular price $750.00 USDRegular priceUnit price per -
Escherichia coli bacteriophage 100784F
Regular price $650.00 USDRegular priceUnit price per -
Escherichia coli bacteriophage 100785F
Regular price $750.00 USDRegular priceUnit price per -
Escherichia coli bacteriophage 100785G
Regular price $750.00 USDRegular priceUnit price per -
Escherichia coli bacteriophage 100786F
Regular price $750.00 USDRegular priceUnit price per -
Escherichia coli bacteriophage 100789F
Regular price $600.00 USDRegular priceUnit price per -
Escherichia coli bacteriophage 100791F
Regular price $650.00 USDRegular priceUnit price per -
Escherichia coli bacteriophage 100792F
Regular price $600.00 USDRegular priceUnit price per -
Escherichia coli bacteriophage 100793F
Regular price $750.00 USDRegular priceUnit price per -
Escherichia coli bacteriophage 100794F
Regular price $750.00 USDRegular priceUnit price per -
Escherichia coli bacteriophage 100795F
Regular price $600.00 USDRegular priceUnit price per -
Escherichia coli bacteriophage 100796F
Regular price $700.00 USDRegular priceUnit price per -
Escherichia coli bacteriophage 100800F
Regular price $800.00 USDRegular priceUnit price per -
Escherichia coli bacteriophage 100801F
Regular price $750.00 USDRegular priceUnit price per -
Escherichia coli bacteriophage 100802F
Regular price $750.00 USDRegular priceUnit price per